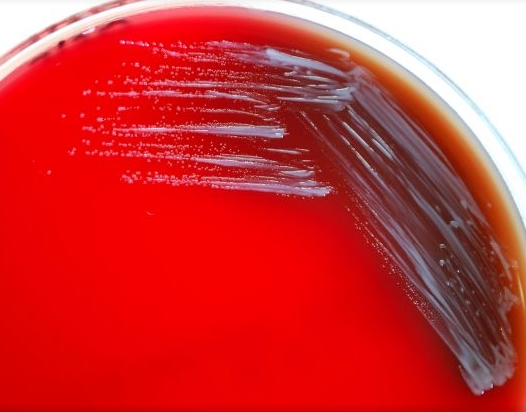
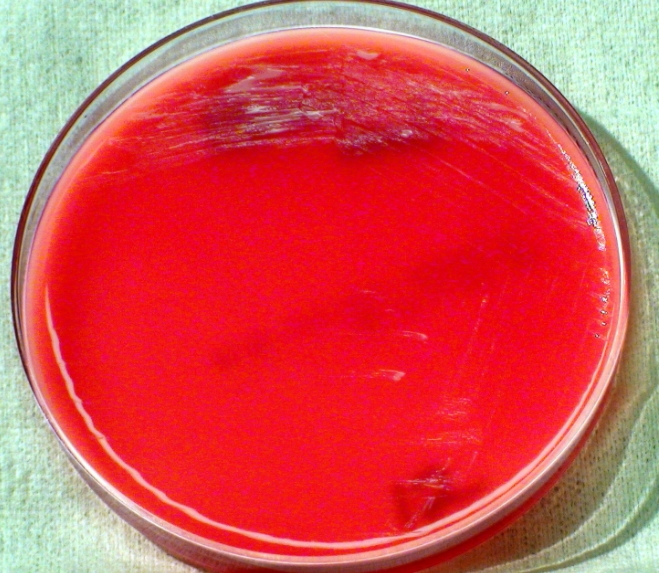

브루셀라 병이란

사람과 동물 모두가 걸릴 수 있는 인수공통감염병인 브루셀라 병이란 것이 중국에서 또 발생해서 많은 사람이 감염되었다는 뉴스를 보았습니다.
우리나라에서도 제3군 법정감염병으로 분류되어 있다고 하는 이 브루셀라 병이란 어떤 증상을 나타내는지 어떤 경로를 거쳐서 감염되는지, 그리고 그 원인과 치료에 관해 소개합니다.


브루셀라 병이란 그램음성세균인 브루셀라속 브루셀라세균의 몇개 균종으로 발생하는 감염병으로 발열과 전신증상이 나타나게 됩니다.
감염되는 경로 및 원인은 감염된 동물과 접촉하거나 감염된 우유나 유제품을 살균하지 않고 섭취하거나 오염된 고기를 충분히 가열하지 않은 상태에서 먹어서 사람이 감염됩니다.
브루셀란 병이란 증상은 발열, 오한, 심한 두통 그리고 요통과 관절통 그리고 온갖 뼈마디가 다 아프다는 증상을 호소하게 되는 전신증상이 나타나는 것이 특징입니다.


좀더 자세히 브루셀라 병 증상을 이야기하면 갑자기 증상이 나타나는데 오한, 잠잘 때 땀, 심한 두통, 요통, 뼈마디 쑤심, 관절통 등과 함께 설사도 나타납니다.
하지만 서서히 그 증상이 나타나기도 하는데 이때는 컨디션이 나쁘다는 정도에 근육통, 두통, 목뒤통증이 나타납니다. 그리고 몇 주간에 걸쳐 열이 났다가 가라앉는 등의 증상이 반복됩니다.


브루셀라 병 후기 증상은 식욕부진, 체중감소, 심한 변비, 복통, 관절통, 수면곤란, 피로감, 우울 등의 증상이 있습니다. 또한 가끔은 뇌와 뇌막, 추골, 대퇴골, 관절, 심장판막 그 외 장기가 감염되기도 합니다.


이렇게 장지나 조직이 감염되지 않는다면 대부분의 경우 치료하지 않아도 2~3주 정도로 회복되는 병이기도 합니다. 하지만 증상이 낫지 않는 경우도 있습니다. 브루셀라 병 환자의 약 5%는 사망에 이른다고도 하는데 이는 뇌, 뇌막, 심장판막이 감염되었을 경우입니다.
혈액검사나 배양검사 등으로 진단을 내릴 수 있습니다. 하지만 몇개월 또는 몇년에 걸쳐 몇번 반복되어 발열증상이 나타납니다.

사실 이 브루셀라 병이란 미국이나 캐나다, 유럽 등에서는 드물게 나타나지만 중동지방과 멕시코, 중남미 그리고 중국 등에서는 보다 더 많이 발생하고 있습니다.
감염된 개, 사슴, 물소 등과 접촉하거나 세균이 포함되어 있는 공기중 입자를 흡입하는 등으로도 브루셀라 병 감염되는 경우도 있지만 사람에서 사람으로 전염되는 일은 거의 없습니다.